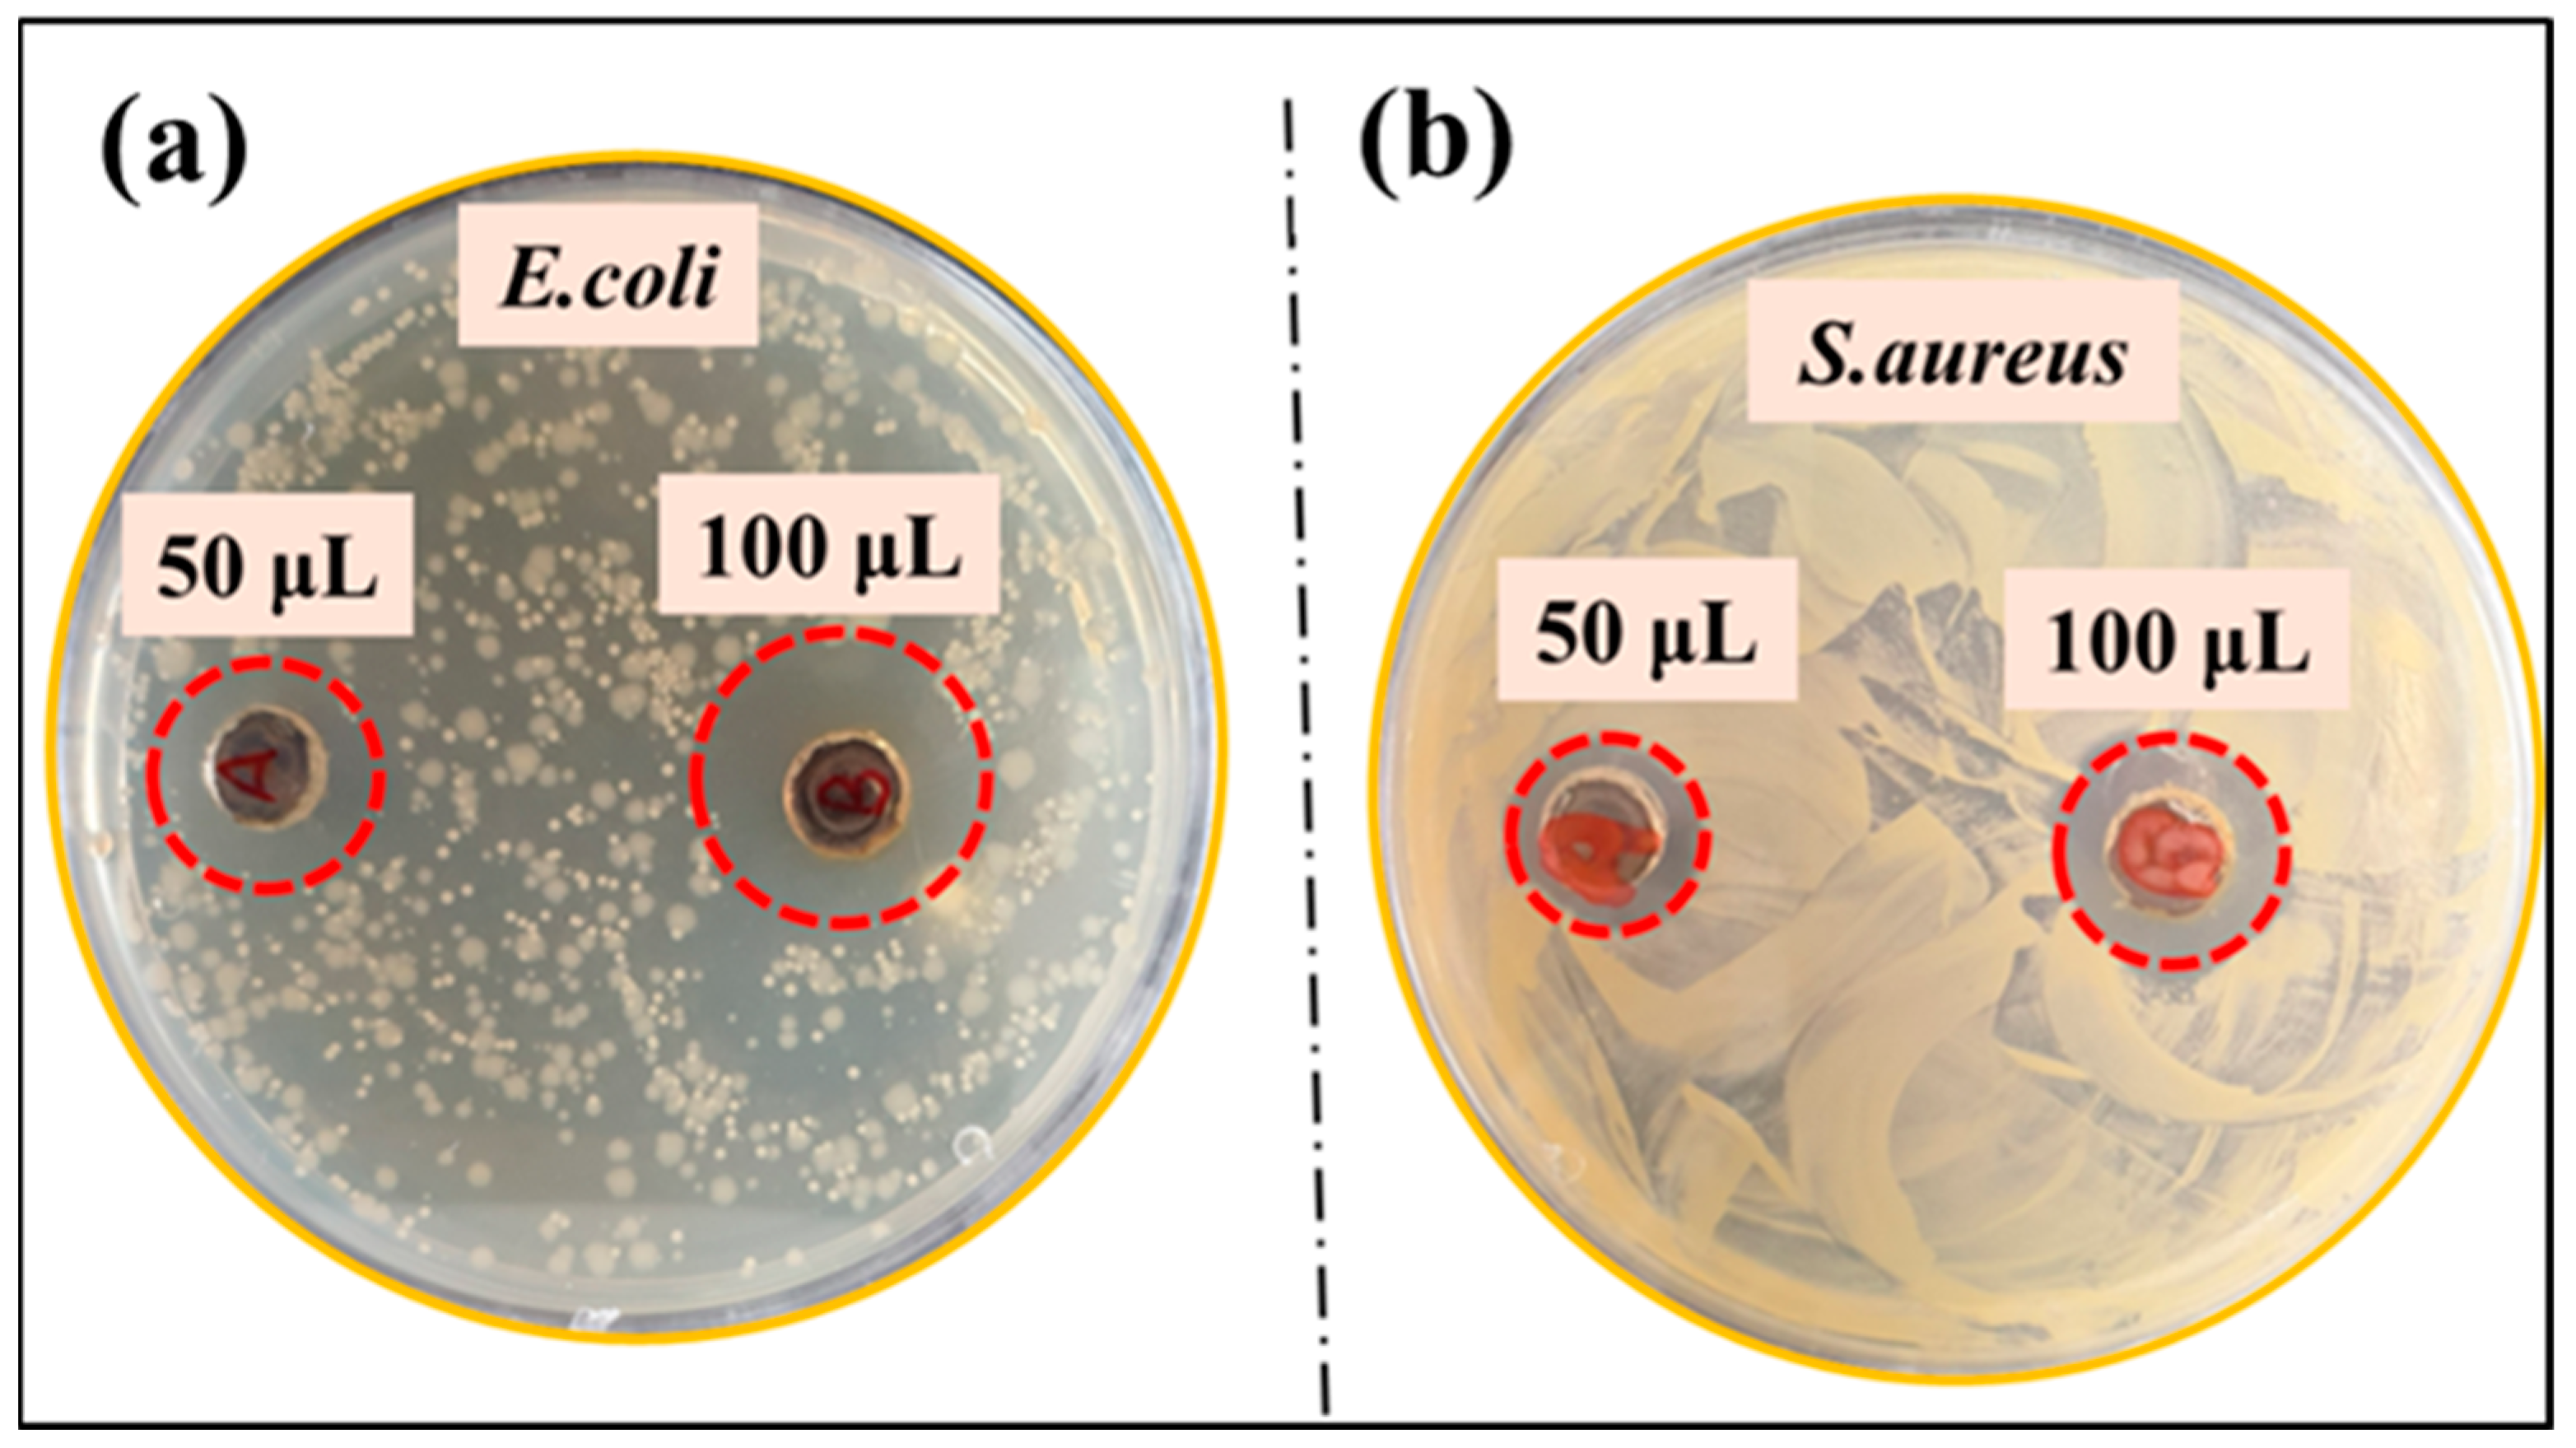

Green Synthesis of Copper Oxide Nanoparticles from Waste Solar Panels Using Piper nigrum Fruit Extract and Their Antibacterial Activity
Abstract
1. Introduction
2. Results and Discussion
2.1. Leaching
2.2. Mechanism for Synthesis of Copper Oxide Nanoparticles by Plant Extract
2.3. EDS
2.4. FTIR
2.5. XRD
2.6. Zeta Potential
2.7. Antibacterial Activity
3. Materials and Methods
3.1. Materials
3.2. Antibacterial Activity of Copper Oxide Nanoparticles
3.2.1. Cultivation of Bacterial Strains
3.2.2. Agar Well-Diffusion Method
3.3. Leaching of Copper Metal from Solar Panel
3.4. Fruit Extraction of Piper nigrum
3.5. Synthesis of Copper Oxide Nanoparticles
3.6. Characterization of Piper nigrum Mediated Copper Oxide Nanoparticles
4. Conclusions
Author Contributions
Funding
Data Availability Statement
Conflicts of Interest
References
- IRENA_IEAPVPS_End-of-Life_Solar_PV_Panels_2016. Available online: https://www.irena.org/-/media/Files/IRENA/Agency/Publication/2016/IRENA_IEAPVPS_End-of-Life_Solar_PV_Panels_2016.pdf (accessed on 26 June 2024).
- Gautam, A.; Shankar, R.; Vrat, P. End-of-Life Solar Photovoltaic e-Waste Assessment in India: A Step towards a Circular Economy. Sustain. Prod. Consum. 2021, 26, 65–77. [Google Scholar] [CrossRef]
- Sah, D.; Chitra; Kumar, S. Investigation and Recovery of Copper from Waste Silicon Solar Module. Mater. Chem. Phys. 2023, 296, 127205. [Google Scholar] [CrossRef]
- Ali, A.; AlZahrani, A.; Khan, M.W.; Sahaf, H.S.; Khalid, M.; Islam, A. Recycling and Material Extraction from End-of-Life Photovoltaic Modules Waste: Exploring Physical Recovery Techniques. In Proceedings of the 2024 IEEE 1st Karachi Section Humanitarian Technology Conference (KHI-HTC), Tandojam, Pakistan, 8 January 2024; pp. 1–7. [Google Scholar]
- Pagnanelli, F.; Moscardini, E.; Granata, G.; Abo Atia, T.; Altimari, P.; Havlik, T.; Toro, L. Physical and Chemical Treatment of End of Life Panels: An Integrated Automatic Approach Viable for Different Photovoltaic Technologies. Waste Manag. 2017, 59, 422–431. [Google Scholar] [CrossRef] [PubMed]
- Azeumo, M.F.; Germana, C.; Ippolito, N.M.; Franco, M.; Luigi, P.; Settimio, S. Photovoltaic Module Recycling, a Physical and a Chemical Recovery Process. Sol. Energy Mater. Sol. Cells 2019, 193, 314–319. [Google Scholar] [CrossRef]
- Liu, F.-W.; Cheng, T.-M.; Chen, Y.-J.; Yueh, K.-C.; Tang, S.-Y.; Wang, K.; Wu, C.-L.; Tsai, H.-S.; Yu, Y.-J.; Lai, C.-H.; et al. High-Yield Recycling and Recovery of Copper, Indium, and Gallium from Waste Copper Indium Gallium Selenide Thin-Film Solar Panels. Sol. Energy Mater. Sol. Cells 2022, 241, 111691. [Google Scholar] [CrossRef]
- Saleem, M.H.; Ejaz, U.; Vithanage, M.; Bolan, N.; Siddique, K.H.M. Synthesis, Characterization, and Advanced Sustainable Applications of Copper Oxide Nanoparticles: A Review. Clean. Technol. Environ. Policy 2024. [Google Scholar] [CrossRef]
- Rubilar, O.; Rai, M.; Tortella, G.; Diez, M.C.; Seabra, A.B.; Durán, N. Biogenic Nanoparticles: Copper, Copper Oxides, Copper Sulphides, Complex Copper Nanostructures and Their Applications. Biotechnol. Lett. 2013, 35, 1365–1375. [Google Scholar] [CrossRef] [PubMed]
- Ashokkumar, K.; Murugan, M.; Dhanya, M.K.; Pandian, A.; Warkentin, T.D. Phytochemistry and Therapeutic Potential of Black Pepper [Piper nigrum (L.)] Essential Oil and Piperine: A Review. Clin. Phytosci. 2021, 7, 52. [Google Scholar] [CrossRef]
- Srivastava, A.K.; Singh, V.K. Biological Action of Piper nigrum-the King of Spices. Eur. J. Biol. Res. 2017, 7, 223–233. [Google Scholar] [CrossRef]
- Kiranmayee, M.; Rajesh, N.; Vidya Vani, M.; Khadri, H.; Mohammed, A.; Chinni, S.V.; Ramachawolran, G.; Riazunnisa, K.; Moussa, A.Y. Green Synthesis of Piper nigrum Copper-Based Nanoparticles: In Silico Study and ADMET Analysis to Assess Their Antioxidant, Antibacterial, and Cytotoxic Effects. Front. Chem. 2023, 11, 1218588. [Google Scholar] [CrossRef]
- Sreeja, C.; Philip, K.A.; Shamil, K.; Asraj, O.P.; Sreeja, S. Pepper Leaf Extract Assisted Green Synthesis of Copper Nano Particles-Synthesis and Characterisation; AIP Publishing: Long Island, NY, USA, 2020; p. 020004. [Google Scholar]
- Yi, Y.K.; Kim, H.S.; Tran, T.; Hong, S.K.; Kim, M.J. Recovering Valuable Metals from Recycled Photovoltaic Modules. J. Air Waste Manag. Assoc. 2014, 64, 797–807. [Google Scholar] [CrossRef]
- Habbache, N.; Alane, N.; Djerad, S.; Tifouti, L. Leaching of Copper Oxide with Different Acid Solutions. Chem. Eng. J. 2009, 152, 503–508. [Google Scholar] [CrossRef]
- Din, M.I.; Arshad, F.; Hussain, Z.; Mukhtar, M. Green Adeptness in the Synthesis and Stabilization of Copper Nanoparticles: Catalytic, Antibacterial, Cytotoxicity, and Antioxidant Activities. Nanoscale Res. Lett. 2017, 12, 638. [Google Scholar] [CrossRef] [PubMed]
- Ganesh, P.; Suresh Kumar, R.; Saranraj, P. Phytochemical Analysis and Antibacterial Activity of Pepper (Piper nigrum L.) against Some Human Pathogens. Sch. Res. Libr. Cent. Eur. J. Exp. Biol. 2014, 3, 36–41. [Google Scholar]
- Mariselvi, S.; Manimegalai, K. Phytochemical screening and xrd analysis of black pepper. Piper Nigrum. Int. J. Curr. Adv. Res. [CrossRef]
- Suzery, M.; Ria, R.Y.S.; Cahyono, B. Alkaloids Piperine in Dichloromethane Fraction of Red Galangal Rizhome (Alpinia Purpurata). In Proceedings of the IOP Conference Series: Materials Science and Engineering; Institute of Physics Publishing: Bristol, UK, 2019; Volume 509. [Google Scholar]
- Elango, M.; Deepa, M.; Subramanian, R.; Mohamed Musthafa, A. Synthesis, Characterization, and Antibacterial Activity of Polyindole/Ag–Cuo Nanocomposites by Reflux Condensation Method. Polym. Plast. Technol. Eng. 2018, 57, 1440–1451. [Google Scholar] [CrossRef]
- Mohammed, G.J.; Omran, A.M.; Hussein, H.M. Antibacterial and Phytochemical Analysis of Piper nigrum Using Gas Chromatography-Mass Spectrum and Fourier-Transform Infrared Spectroscopy. Int. J. Pharmacogn. Phytochem. Res. 2016, 8, 10. [Google Scholar]
- Joshi, V.; Bachhar, V.; Mishra, S.S.; Shukla, R.K.; Gangal, A.; Duseja, M. GC–MS Fingerprinting, Nutritional Composition, in Vitro Pharmacological Activities and Molecular Docking Studies of Piper Chaba from Uttarakhand Region. 3 Biotech. 2024, 14, 158. [Google Scholar] [CrossRef] [PubMed]
- Aziz, D.M.; Hama, J.R.; Alam, S.M. Synthesising a Novel Derivatives of Piperine from Black Pepper (Piper nigrum L.). J. Food Meas. Charact. 2015, 9, 324–331. [Google Scholar] [CrossRef]
- Manjusha, S.; Parameswaran, N.K.; Senthil Malar, R. Determination Of Bioactive Compounds From Piper nigrum L By Using FT-IR Spectroscopic Analysis. Indo Am. J. Pharm. Sci. 2018, 5, 2919–2921. [Google Scholar] [CrossRef]
- Alhalili, Z. Green Synthesis of Copper Oxide Nanoparticles CuO NPs from Eucalyptus Globoulus Leaf Extract: Adsorption and Design of Experiments. Arab. J. Chem. 2022, 15, 103739. [Google Scholar] [CrossRef]
- Al-Qasmi, N. Facial Eco-Friendly Synthesis of Copper Oxide Nanoparticles Using Chia Seeds Extract and Evaluation of Its Electrochemical Activity. Processes 2021, 9, 2027. [Google Scholar] [CrossRef]
- Kumar, A.; Saxena, A.; De, A.; Shankar, R.; Mozumdar, S. Facile Synthesis of Size-Tunable Copper and Copper Oxide Nanoparticles Using Reverse Microemulsions. RSC Adv. 2013, 3, 5015–5021. [Google Scholar] [CrossRef]
- Asamoah, R.B.; Yaya, A.; Mensah, B.; Nbalayim, P.; Apalangya, V.; Bensah, Y.D.; Damoah, L.N.W.; Agyei-Tuffour, B.; Dodoo-Arhin, D.; Annan, E. Synthesis and Characterization of Zinc and Copper Oxide Nanoparticles and Their Antibacteria Activity. Results Mater. 2020, 7, 100099. [Google Scholar] [CrossRef]
- Ahamed, M.; Alhadlaq, H.A.; Khan, M.A.M.; Karuppiah, P.; Al-Dhabi, N.A. Synthesis, Characterization, and Antimicrobial Activity of Copper Oxide Nanoparticles. J. Nanomater. 2014, 2014, 637858. [Google Scholar] [CrossRef]
- Halawani, E.M. Rapid Biosynthesis Method and Characterization of Silver Nanoparticles Using Zizyphus Spina Christi Leaf Extract and Their Antibacterial Efficacy in Therapeutic Application. J. Biomater. Nanobiotechnol. 2017, 8, 22–35. [Google Scholar] [CrossRef]
- Filippov, S.K.; Khusnutdinov, R.; Murmiliuk, A.; Inam, W.; Zakharova, L.Y.; Zhang, H.; Khutoryanskiy, V.V. Dynamic Light Scattering and Transmission Electron Microscopy in Drug Delivery: A Roadmap for Correct Characterization of Nanoparticles and Interpretation of Results. Mater. Horiz. 2023, 10, 5354–5370. [Google Scholar] [CrossRef]
- Bin Mobarak, M.; Hossain, M.S.; Chowdhury, F.; Ahmed, S. Synthesis and Characterization of CuO Nanoparticles Utilizing Waste Fish Scale and Exploitation of XRD Peak Profile Analysis for Approximating the Structural Parameters. Arab. J. Chem. 2022, 15, 104117. [Google Scholar] [CrossRef]
- Elamawi, R.M.; Al-Harbi, R.E.; Hendi, A.A. Biosynthesis and Characterization of Silver Nanoparticles Using Trichoderma Longibrachiatum and Their Effect on Phytopathogenic Fungi. Egypt. J. Biol. Pest. Control 2018, 28, 28. [Google Scholar] [CrossRef]
- Naaz, S.; Shet, V.B.; Mubarak, N.M. Green Synthesis of Copper Oxide Nanoparticles: Characterization and Applications for Environmental and Biomedical Fields. Can. J. Chem. Eng. 2024, 102, 1454–1465. [Google Scholar] [CrossRef]
- Jadhav, S.; Gaikwad, S.; Nimse, M.; Rajbhoj, A. Copper Oxide Nanoparticles: Synthesis, Characterization and Their Antibacterial Activity. J. Clust. Sci. 2011, 22, 121–129. [Google Scholar] [CrossRef]
- Abbas, S.F.; Haider, A.J.; Al-Musawi, S.; Selman, M.K. Antibacterial Effect of Copper Oxide Nanoparticles Prepared by Laser Production in Water Against Staphylococcus Aureus and Escherichia Coli. Plasmonics 2023. [Google Scholar] [CrossRef]
- Lin, Y.E.; Vidic, R.D.; Stout, J.E.; McCartney, C.A.; Yu, V.L. Inactivation of Mycobacterium Avium by Copper and Silver Ions. Water Res. 1998, 32, 1997–2000. [Google Scholar] [CrossRef]
- Deshmukh, A.R.; Gupta, A.; Kim, B.S. Ultrasound Assisted Green Synthesis of Silver and Iron Oxide Nanoparticles Using Fenugreek Seed Extract and Their Enhanced Antibacterial and Antioxidant Activities. Biomed. Res. Int. 2019, 2019, 1714358. [Google Scholar] [CrossRef] [PubMed]
- Quan, Z.; Lu, H.; Zhao, W.; Zheng, C.; Zhu, Z.; Qin, J.; Yue, M. A Review of Dust Deposition Mechanism and Self-Cleaning Methods for Solar Photovoltaic Modules. Coatings 2022, 13, 49. [Google Scholar] [CrossRef]

Disclaimer/Publisher’s Note: The statements, opinions and data contained in all publications are solely those of the individual author(s) and contributor(s) and not of MDPI and/or the editor(s). MDPI and/or the editor(s) disclaim responsibility for any injury to people or property resulting from any ideas, methods, instructions or products referred to in the content. |
© 2024 by the authors. Licensee MDPI, Basel, Switzerland. This article is an open access article distributed under the terms and conditions of the Creative Commons Attribution (CC BY) license (https://creativecommons.org/licenses/by/4.0/).
Share and Cite
Shafiq, A.; Jeong, U.; Han, Y.; Kim, Y.; Lee, J.; Kim, B.S. Green Synthesis of Copper Oxide Nanoparticles from Waste Solar Panels Using Piper nigrum Fruit Extract and Their Antibacterial Activity. Catalysts 2024, 14, 472. https://doi.org/10.3390/catal14080472
Shafiq A, Jeong U, Han Y, Kim Y, Lee J, Kim BS. Green Synthesis of Copper Oxide Nanoparticles from Waste Solar Panels Using Piper nigrum Fruit Extract and Their Antibacterial Activity. Catalysts. 2024; 14(8):472. https://doi.org/10.3390/catal14080472
Chicago/Turabian StyleShafiq, Ayesha, Ujin Jeong, Yunseon Han, Youngsik Kim, Joonmin Lee, and Beom Soo Kim. 2024. "Green Synthesis of Copper Oxide Nanoparticles from Waste Solar Panels Using Piper nigrum Fruit Extract and Their Antibacterial Activity" Catalysts 14, no. 8: 472. https://doi.org/10.3390/catal14080472
APA StyleShafiq, A., Jeong, U., Han, Y., Kim, Y., Lee, J., & Kim, B. S. (2024). Green Synthesis of Copper Oxide Nanoparticles from Waste Solar Panels Using Piper nigrum Fruit Extract and Their Antibacterial Activity. Catalysts, 14(8), 472. https://doi.org/10.3390/catal14080472





